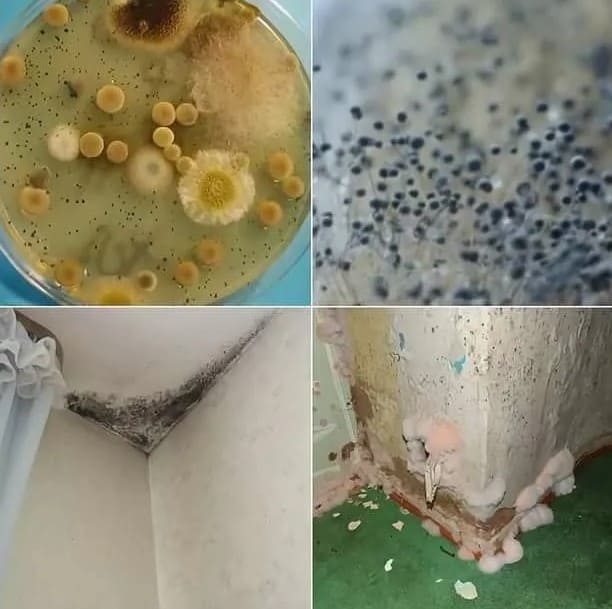

Уничтожение грибка и плесени
Обработка от плесени и грибка в Магнитогорске
Очень часто в квартире, особенно в ванной комнате, кухне можно заметить появление нежелательных чёрных пятен или крапин. Это тревожный симптом, который говорит о наличии плесени и грибка. Явление, которое может принести массу неудобств своему хозяину и стать причиной болезней и дискомфорта. А если речь идёт об общественном месте (бассейны, сауны, бани, салоны красоты) то и до полного закрытия организации может дойти дело. Очень часто справиться с плесенью самостоятельно не получается. Скорее всего эффект будет кратковременным, и вскоре она вернётся вновь. Будут потрачены средства и будет потрачено время, а проблема не будет решена. Гораздо выгоднее и целесообразнее обратиться к специалистам. Профессиональные фирмы, как наша, оказывают подобного рода услуги. Грамотные сотрудники нашей компании избавят вас от плесени и грибка за один день. Проведут все необходимые меры профилактики и вы забудете о надоедливой проблеме навсегда.
ЦЕНА ОБРАБОТКА ПЛЕСЕНИ В КВАРТИРЕ
Стоимость услуги складывается и нескольких факторов: размер помещения, вид плесени, степень загрязнения, удалённость от центра города. Вы всегда можете получить актуальную информацию по нашему телефону или у нас на сайте.
Проводится микологическая экспертиза, определяющая вид грибка, наиболее эффективный способ обработкиа и подходящий препарат. У нас есть собственные лаборатории, где наши сотрудники проведут все необходимые анализы. Наши цены фиксируется в договоре. Вы можете быть уверены, что цена не поменяется после осмотра помещения. Предоставляется скидка социальной категории граждан, инвалидам, на вторую услугу до 50%. Средняя стоимость процедуры 1 м.кв. составляет 1000 рублей без очистки поверхности и 1800 с полным удалением плесени. Объемные заказы более 20 м.кв. рассчитываются по договоренности.
Места обработки от грибка и плесени
Плесень частый гость в жилых домах и производственных помещениях. Чаще всего она появляется в ветхом и старом пространстве. Может появиться в новостройке, если нарушена вентиляция. Конечно наличие плесени не обрадует никакого хозяина. Помимо эстетического вида она может быть источником болезни и принести вред своему хозяину. Велик риск образования плесени в ванных комнатах, на кухне рядом с раковиной. Везде где есть вода или конденсат.
Ванная
В те места, куда попадают струи воды может образоваться плесень. Могут быть поражены уголки комната, пол, плинтус, холодная часть стены, верхняя часть потолка. Часто плесень базируется в нижних углах комнаты, куда попадают в струи воды или в верхних частях, где остается пар. Вода не испаряется и не уходит, система обогрева работает плохо и это может стать причиной образования плесени.
система обогрева работает плохо и это может стать причиной образования плесени.
Балкон
Очень часто остекление балкона является причиной образования конденсата. Именно лишняя влага может стать причиной образования плесени на балконе. Искать её следует в нижней части стен, в верхней части стен, на потолке.
Баня
В бане также возможно лишнее скопление влаги. А самое опасное, что плесень моментально разъедать дерево и необходимо принимать срочные меры по борьбе с плесенью на деревянных конструкциях.
Опасность плесени в квартире
Очень часто плесень появляются в квартире и жильцы не придают ей большого значения. Кроме визуального дискомфорта плесень может стать причиной ряда заболеваний. Она может вызывать аллергию, кожные высыпания, расстройство ЖКТ, стать причиной язв, оказывать влияние на общее состояние человека и на снижение иммунитета. Так как опасные и болезнетворные бактерии летают в воздухе.
Грибки и плесень очень быстро размножаются, от отдельные элементы могут проникать в пищу, и оказывать влияние на здоровье человека. Особенно опасна плесень для пожилых людей, детей, людей, у которых ослаблен иммунитет. Вирусы и бактерии могут разрушать организм и причинить сильный вред. Плесень - это очень живучие грибки, которые могут приспособиться к любым условиям. Плесень не боится Холодов. Может жить на любых поверхностях, неважно какой у них состав. Если уничтожение плесени и грибка заказать в Магнитогорске и Челябинской области при первых ее проявлениях, сразу обратившись к профессионалам Санитарной Эпидемиологической Службы, то положительный результат гарантирован и удастся спасти большую часть декора. Если не сделать это вовремя можно не только лишиться любимых предметов интерьера, но и сильно пострадать и ослабить свое здоровье и здоровье своих близких.
Самостоятельно справиться с плесенью практически невозможно, так как локальная протирания, как правило, не помогает. Грибки поселяются глубоко внутри и вы можете убрать их с поверхности предмета, но со временем плесень вернётся вновь. В итоге будет жаль потраченного времени и потраченных сил, а результата вы не достигнете. Необходимо доверить работу квалифицированным специалистам, которые разбираются в видах плесени и знают как с ней бороться.
Виды плесени
 Плесень различается по месту обитания и распространения. Видов племени множество. Степень повреждений также колоссальна. Споры этих микроорганизмов есть практически везде. Они находятся в воздухе, оседают на одежде и любых поверхностях, продуктах питания. Очень быстро размножаются, когда созданы благоприятные условия. Отличаются по цвету и составу, очень быстро повреждают поверхность и разрастаются. А вывести самостоятельно их практически невозможно. Рассмотрим виды плесени.
Плесень различается по месту обитания и распространения. Видов племени множество. Степень повреждений также колоссальна. Споры этих микроорганизмов есть практически везде. Они находятся в воздухе, оседают на одежде и любых поверхностях, продуктах питания. Очень быстро размножаются, когда созданы благоприятные условия. Отличаются по цвету и составу, очень быстро повреждают поверхность и разрастаются. А вывести самостоятельно их практически невозможно. Рассмотрим виды плесени.
Черная. Грибница белая, темные – споры. В медицине это плесень очень важно, так как она является источником антибиотиков. Но в квартире может вызывать опасные болезни и сильно вредить. Может провоцировать пищевые отравления и аллергию. Не имеет цвет на ранних этапах зарождения. Её трудно обнаружить. Очень неприхотлива в своих условиях, обладает высокой выносливостью, может жить в любых условиях, она устойчива ко многим средством борьбы с плесенью, которые продается на рынке.
Зеленая плесень чаще всего обнаруживается в почве или в самых разных органических материалах. Стремительно развивается и проникает вглубь тканей, заражая их полностью. Наблюдается на фруктах, обосновывается на строительных материалах, предпочитая дерево, и начинает постепенно разрушать их.
Розовая выглядит привлекательно, но скрывает не менее разрушительный потенциал. В основном любит зерно и крупы и растительные остатки.
Белая плесень в качестве места обитания выбирает почву комнатных растений, сыр и хлеб. Не так опасна, как предыдущие виды, но бороться с ней нужно.
Голубая даже приносит пользу, поскольку используется для приготовления отдельных видов продукции сыроварен. Располагается на деревянных элементах, быстро разрушая структуру.
Серая считается наиболее опасной, при первых же признаках ее возникновения в помещении немедленно вызывается бригада дезинфекторов.
Причины появления плесени в квартире
Плесень очень любит влажность и высокую температуру. В помещении, где нарушена вентиляция или недостаточная циркуляция воздуха плесень живёт с большим удовольствием. Чердаки, кладовые, подвалы, кухни и ванные самый частые места обитания плесени. При этом не важно, повышен ли общий фон или такая обстановка сложилась в локальном пространстве. Это может произойти при: очень холодных стенок, при наличии конденсата, текут трубы, неправильно установлены пластиковые окна, холодное помещение.
Стоит учесть, что нужно устранить предпосылки появления плесени, иначе вызывать дезинфекторов придется с завидной регулярностью.
Когда необходимо вызывать службу дезинфекции
Если вы заметили, что состояние здоровья сильно ухудшилось, вас беспокоят неприятный запах, головные боли, тёмные пятна на мебели и стенах, то необходимо обратиться в специализированную службу. Внешне вы можете увидеть лишь видимую часть плесени, необходимо понимать, что основная колония прячется намного глубже. Самостоятельно удалить плесень невозможно, поэтому на данном этапе нужно обратиться к специалистам. Благодаря современным технологиям и качественным препаратом мы избавим вас от плесени раз и навсегда. Наши препараты действует локально и уничтожают глубинные проявления плесени.
Древнейшие микроорганизмы, способные пережить радиацию, критические температуры, выживать в условиях открытого космоса, очень уютно чувствуют себя при влажности воздуха и конструкций в пределах 60-80%, а также в отсутствие вентиляции. Необходима тотальная очистка и профилактическая санация, поскольку многие разновидности токсичны.
Профессиональные методы уничтожения плесени в Магнитогорске
Горячий туман – это самый распространённый метод для борьбы с плесенью. 1000 наших клиентов подтвердили качество нашей работы своими отзывами. Мы используем европейские средства и современное оборудование, которое соответствует стандартам качества. Благодаря этому удаляем плесень быстро и эффективно.
Генератор горячего тумана – это, сухой метод. Вы можете не волноваться, этот метод не портит мебель истины. Абсолютно безопасен для человека. С помощью специального генератора химическое средство, в нагретом состоянии, распаляется в комнате, таким образом попадая в самые труднодоступные места. Под действием температуры химические препараты намного эффективнее удаляют грибки плесень.
Есть менее дорогой вариант он называется холодный туман и действует примерно так же. Средство распыляется с помощью генератора в воздухе, оседает на предметах, мелкие капли уничтожают плесень и грибок. Химические препараты используются 4 класса безопасности, они не наносит вред человеку, а с плесенью борются моментально.
Преимущества нашей компании Городской СЭС-Станции в Магнитогорске
Если вы хотите самостоятельно удалить плесень, то скорее всего потратите время и нервы. Потому что физические средства, такие как обтирание локальное и местное, не действуют на этот грибок. Необходимо работать специальными препаратами. Такие препараты не продаются на рынке и в магазинах для общего пользования. Чтобы с ними работать необходима лицензия. У нас она есть. Обращение к нашим специалистам дает: быстрое реагирование после звонка, грамотный подбор средств, оценка специалиста, современное оборудование, качество результата, гарантия.
Многие наши клиенты обратились к нам впервые и были довольны качеством услуг, оставили хорошие отзывы. Квалификация наших сотрудников на высоком уровне, так как у нас работают профессионалы своего дела, которые уже давно в этой сфере.
Процесс предоставления услуги: прием заявки, консультация, выезд специалиста, оценка объекта, заключения договора. Мы действуем оперативно и качественно. Можем гарантировать 100 %результат ссылаясь на положительные отзывы наших клиентов.
- позвонить 8 (921) 792 48 34
- написать нам ses-magnitogors@yandex.ru
- или оставить заявку на сайте